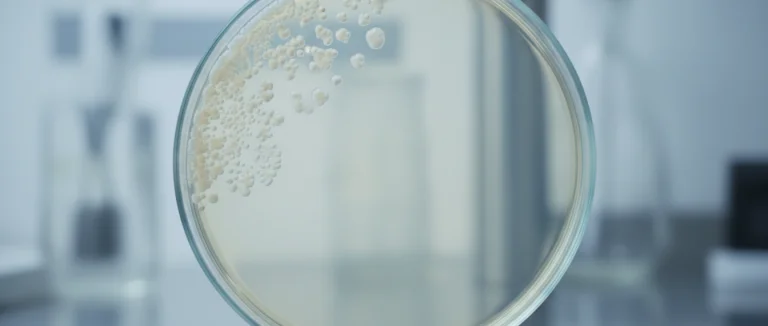
Дисбаланс микрофлоры кишечника под действием антибиотика

Амоксициллин и инфекция мочевых путей: риски и советы
-
Как работает амоксициллин и когда он назначается
-
Что такое инфекция мочевых путей и её основные причины
-
Может ли амоксициллин способствовать развитию ИМП?
-
Как отличить побочные эффекты амоксициллина от симптомов ИМП
-
Что делать
-
если подозреваете ИМП при приёме амоксициллина
-
Почему Выбирают Лив Хоспитал
Вопрос может ли амоксициллин вызвать инфекцию мочевых путей часто задают пациенты, получающие антибиотик при различных инфекциях. Амоксициллин широко применяется в терапии бактериальных заболеваний, однако его влияние на микрофлору мочевого тракта вызывает опасения.
В этой статье мы разберём, как работает препарат, какие механизмы могут способствовать развитию ИМП, как отличить побочные реакции от настоящей инфекции и какие меры следует предпринять, если симптомы появились во время лечения.
Согласно статистике, более 10 % пациентов, получающих широкоспектральные антибиотики, отмечают изменения в работе мочеполовой системы. Понимание причин поможет избежать осложнений и своевременно обратиться за медицинской помощью.
Как работает амоксициллин и когда он назначается
Амоксициллин относится к группе пенициллиновых антибиотиков и обладает широким спектром действия против грамположительных и некоторых грамнегативных бактерий. Препарат подавляет синтез бактериальной клеточной стенки, что приводит к гибели микроорганизмов.
Основные показания для назначения амоксициллина включают:
- Острые инфекции дыхательных путей (фарингит, бронхит)
- Синуситы и отиты
- Кожные и мягкотканные инфекции
- Некоторые желудочно-кишечные инфекции, вызванные чувствительными штаммами
Дозировка подбирается индивидуально, обычно 500 мг 2‑3 раза в день в течение 7‑10 дней. При правильном применении препарат эффективно устраняет патогены, однако длительный или необоснованный приём может нарушить естественный баланс микрофлоры.

Что такое инфекция мочевых путей и её основные причины
Инфекция мочевых путей (ИМП) – это воспалительное заболевание, вызываемое проникновением патогенных бактерий в мочевой тракт. Наиболее частой причиной является Escherichia coli, однако могут быть задействованы и другие микроорганизмы.
Ключевые факторы риска включают:
| Фактор | Как влияет |
|---|---|
| Нарушение микрофлоры | Снижение количества «дружелюбных» бактерий, позволяющих патогенам колонизироваться |
| Недостаточная гигиена | Упрощает попадание бактерий в уретру |
| Анатомические особенности | Укороченный уретральный канал у женщин облегчает доступ бактерий |
| Иммунодефицит | Сниженная способность организма бороться с инфекциями |
Симптомы ИМП могут включать частое и болезненное мочеиспускание, ощущение неполного опорожнения мочевого пузыря, мутную или кровянистую мочу, а также общую слабость.

Может ли амоксициллин способствовать развитию ИМП?
Прямой причинно-следственной связи между приёмом амоксициллина и возникновением ИМП нет, однако существует несколько механизмов, при которых препарат может повысить вероятность инфекции.
Во-первых, широкоспектральный антибиотик может уничтожать не только патогенные, но и полезные бактерии, обитающие в кишечнике и уретре. Это явление называют дисбиозом. При дисбиозе патогенные штаммы, такие как Enterococcus или устойчивый E. coli, получают возможность колонизировать мочевой тракт.
Во-вторых, длительный курс амоксициллина может привести к развитию резистентных штаммов, которые менее чувствительны к стандартным препаратам и требуют более сложного лечения.
Тем не менее, в большинстве случаев препарат не является непосредственной причиной ИМП. Риск повышается, если у пациента уже есть предрасполагающие факторы, такие как хронические заболевания почек, частые катетеризации или частый приём антибиотиков.
Как отличить побочные эффекты амоксициллина от симптомов ИМП
Побочные реакции амоксициллина часто включают желудочно-кишечные расстройства (тошноту, диарею) и аллергические проявления (кожную сыпь, зуд). Однако некоторые из них могут перекрываться с симптомами инфекции мочевых путей.
Для точного различения рекомендуется обратить внимание на следующее:
- Локализация боли: При ИМП боль обычно ощущается в нижней части живота или в пояснице, а не в желудке.
- Изменения мочи: Помутнение, кровь или сильный запах указывают на инфекцию, а не на обычные побочные эффекты.
- Температура тела: Лихорадка выше 38 °C часто сопутствует ИМП, тогда как при простом побочном эффекте температура обычно нормальна.
- Продолжительность симптомов: Если дискомфорт сохраняется более 48 часов после начала приёма, стоит проверить мочу.
При любой неопределённости рекомендуется сдать анализ мочи и обсудить результаты с врачом.
Что делать, если подозреваете ИМП при приёме амоксициллина
Если во время курса амоксициллина появляются симптомы, напоминающие инфекцию мочевых путей, следует действовать последовательно:
- Прекратить приём препарата только после консультации с врачом.
- Сдать анализ мочи (общий анализ и посев) для подтверждения наличия патогена.
- Обратиться к урологу или нефрологу для уточнения диагноза и подбора целевого антибиотика.
- Поддерживать гидратацию – пить достаточное количество воды помогает вымывать бактерии.
- Избегать раздражающих факторов – сократить потребление кофеина, алкоголя и острых блюд.
В случае подтверждённой ИМП врач может назначить препарат из группы фторхинолонов, нитрофуранов или цефалоспоринов, учитывая чувствительность выявленного микроорганизма.
Важно помнить, что своевременное лечение предотвращает развитие осложнений, таких как пиелонефрит или хроническая инфекция почек.
Почему Выбирают Лив Хоспитал
Лив Хоспитал – аккредитованная JCI сеть частных больниц в Стамбуле, специализирующаяся на комплексном обслуживании иностранных пациентов. Мы предлагаем широкий спектр медицинских услуг, включая диагностику и лечение инфекций мочевых путей с использованием современных методов и индивидуального подхода. Команда опытных урологов и нефрологов обеспечивает высококвалифицированную помощь, а сервисы переводчика, транспортировки и организации проживания делают процесс лечения комфортным и безопасным.
Если у вас возникли вопросы о возможных осложнениях при приёме амоксициллина, запишитесь на консультацию в Лив Хоспитал уже сегодня. Мы поможем подобрать оптимальное лечение и обеспечить полную поддержку на каждом этапе вашего восстановления.
Часто задаваемые вопросы
Амоксициллин – широкоспектральный антибиотик, который уничтожает как патогенные, так и полезные бактерии. При длительном приёме может возникнуть дисбиоз – нарушение микрофлоры кишечника и уретры, что создаёт благоприятные условия для колонизации патогенов, например, устойчивых штаммов E. coli. Кроме того, частый приём антибиотиков повышает риск появления резистентных бактерий, которые труднее лечатся и могут вызвать ИМП. Тем не менее, у большинства пациентов инфекция развивается из‑за других факторов, а не из‑за самого амоксициллина.
Побочные эффекты амоксициллина обычно проявляются в виде желудочно‑кишечных расстройств (тошнота, диарея) и аллергических реакций (сыпь, зуд). При ИМП боль ощущается в нижней части живота или пояснице, а не в желудке. Появление помутнения, крови или сильного запаха в моче указывает на инфекцию. Лихорадка выше 38 °C часто сопутствует ИМП, тогда как при простом побочном эффекте температура обычно нормальна. Если дискомфорт сохраняется более 48 часов, рекомендуется сдать анализ мочи.
Первый механизм – уничтожение «дружелюбных» бактерий в кишечнике и уретре, что приводит к дисбиозу. При отсутствии конкуренции патогенные микроорганизмы, такие как Enterococcus или устойчивый E. coli, легче колонизируют мочевой тракт. Второй механизм – селекция резистентных штаммов при длительном или необоснованном приёме антибиотика. Такие штаммы менее чувствительны к стандартным препаратам и требуют более сложного лечения, повышая риск осложнений.
Во-первых, не прекращайте приём амоксициллина без согласования с врачом. Во‑вторых, необходимо сдать общий анализ мочи и посев для подтверждения наличия патогена. Затем следует обратиться к урологу или нефрологу для уточнения диагноза и подбора целевого антибиотика, учитывающего чувствительность выявленного микроорганизма. Важно поддерживать адекватную гидратацию, пить достаточное количество воды, а также ограничить потребление кофеина, алкоголя и острой пищи, чтобы не раздражать мочевой тракт.
Для профилактики дисбиоза рекомендуется принимать пробиотики, содержащие Lactobacillus и Bifidobacterium, особенно при длительном курсе антибиотиков. Соблюдение личной гигиены, своевременное опорожнение мочевого пузыря и достаточное потребление жидкости снижают риск колонизации патогенов. При наличии факторов риска (частые катетеризации, хронические заболевания почек) следует проводить профилактические анализы мочи. При появлении первых симптомов важно быстро обратиться к врачу, чтобы скорректировать терапию и избежать осложнений.
* Содержимое нашего сайта предназначено только для информационных целей. Обязательно обратитесь к врачу для диагностики и лечения. В содержание страницы не включены элементы, содержащие информацию о терапевтических медицинских услугах в Лив Госпитале.